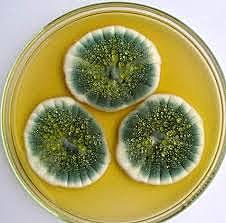
Penicilina

-
Landsteiner
-
Los hermanos Wright conquistan el cielo por 12 segundos despegados a 40 metros del suelo, se les conoce como los pioneros de la aviación en el mundo.
-
A. Einstein formula la teoria de la relatividad especial, que surge de la observación de que la velocidad de la luz en el vacío es igual en todos los sistemas de referencia, y sólo se aplica en el caso especial donde la curvatura del espacio-tiempo debido a la gravedad es despreciable.
-
Walther Nernst, desarrolló el llamado "teorema del calor", según el cual la entropía de una materia tiende a anularse cuando su temperatura se aproxima al cero absoluto, y que constituye la tercera ley de la termodinámica. Recibió el premio Nobel de Química, premio que fue anunciado el 10 de noviembre de 1920 y entregado aquel mismo año.
-
Paul Ehrlich firmó un contrato con Cassella Dye Works para la explotación comercial de los derivados arsenicales que sintetizase fruto de sus investigaciones
-
El Ford T apareció en el mercado el 1 de octubre de 1908 y presentaba una gran cantidad de innovaciones.Todo el motor y la transmisión iban cerrados, los cuatro cilindros estaban encajados en un bloque sólido y la suspensión funcionaba mediante dos muelles semi-elípticos. El automóvil era muy sencillo de conducir y, más importante, muy barato y fácil de reparar.
-
Mientras era profesor en la Universidad de Chicago, Millikan comenzó a trabajar en su experimento con una gota de aceite con objeto de medir la carga del electrón, y con ello su masa y el Número de Avogadro.
-
Lo que precisamente logró Fritz Haber fue transformar ese nitrógeno del aire para hacer amoníaco, para utilizarlo en la fabricación de fertilizantes que las plantas pueden utilizar para crecer, encontrando así una manera de utilizar el nitrógeno del aire para hacer amoníaco, con lo que se hacen los fertilizantes indispensables para la alta producción de cultivos.
Fritz Haber abogó por el uso de cloro y otros gases venenosos como armas contra las tropas aliadas en la guerra de las trincheras. -
Rutherford llegó a la conclusión de que la masa del átomo se concentraba en una región pequeña de cargas positivas que impedían el paso de las partículas alfa. Sugirió un nuevo modelo en el cual el átomo poseía un núcleo o centro en el cual se concentra la masa y la carga positiva, y que en la zona extra nuclear se encuentran los electrones de carga negativa.
-
Descubrió la casi total ausencia de resistencia al paso de la electricidad de ciertas sustancias (mercurio, plomo) a temperaturas cercanas al cero absoluto, fenómeno conocido como superconductividad.
-
La deriva continental es el desplazamiento de las masas continentales unas respecto a otras. Esta hipótesis fue desarrollada por el alemán Alfred Wegener a partir de diversas observaciones, basándose en la manera en que parecen encajar las formas de los continentes a cada lado del océano Atlántico, como África y Sudamérica, de lo que ya se habían percatado anteriormente Benjamin Franklin y otros
-
Leavitt estudió las estrellas variables conocidas como Cefeidas, cuyo brillo varía con periodos regulares, en el Observatorio del Harvard College. Descubrió y catalogó estrellas variables en las Nubes de Magallanes, lo que le permitió deducir en 1912 que las Cefeidas de mayor luminosidad intrínseca tenían largos periodos, estableciendo la relación entre ambas características.
-
Henry Moseley proporcionó un apoyo fundamental al modelo atómico de Bohr definido con detalle por Rutherford y Antonius van den Broek, mencionando que los núcleos atómicos contienen cargas positivas iguales a su número atómico. Su principal contribución a la ciencia fue la justificación cuantitativa del concepto de número atómico mediante la Ley de Moseley.
-
Basándose en las teorías de Ernest Rutherford (átomo de Rutherford) publicó su propio modelo atómico (modelo atómico de Bohr) en 1913, introduciendo la teoría de las órbitas cuantificadas, que en la teoría mecánica cuántica consiste en las características que, en torno al núcleo atómico, el número de electrones en cada órbita aumenta desde el interior hacia el exterior.
-
Max von Laue, desarrolló un método para medir la longitud de onda de los rayos X, utilizando, por primera vez, cristales salinos delgados como retícula de difracción, llegando a demostrar que estos rayos eran de naturaleza análoga a los de la luz, pero no visibles, dado que su longitud de onda es extremadamente corta.
-
William H Bragg demostró que el espectrómetro de rayos X que había construido podía detectar los rayos X monocromáticos difractados, pero no con una placa fotográfica sino con un detector de ionización de gas.
La metodología desarrollada por los Bragg constituía una forma fiable de determinar la estructura interna de todos los sólidos cristalinos y, por tanto, de explicar sus propiedades. -
La solución de Schwarzschild fue la primera solución exacta encontrada para las ecuaciones de la relatividad general.
El radio de Schwarzschild para la masa del Sol es de 3 km mientras que el radio de Schwarzschild de un objeto de la masa terrestre es de tan solo 8,8897 mm. -
La teoría general de la relatividad o relatividad general es una teoría del campo gravitatorio y de los sistemas de referencia generales.
La intuición básica de Einstein fue postular que en un punto concreto no se puede distinguir experimentalmente entre un cuerpo acelerado uniformemente y un campo gravitatorio uniforme. La teoría general de la relatividad permitió también reformular el campo de la cosmología. -
El teorema de Noether explica la conexión fundamental entre la simetría en física y las leyes de conservación.5 A pesar de ello, se le negó la posibilidad de un puesto digno en la universidad por el hecho de ser mujer.
-
Frederick Grant Banting, Charles Best, James Collip, y J.J.R. Macleod de la Universidad de Toronto, Canadá, descubrieron, aislaron y produjeron la insulina.
Por este descubrimiento le fue otorgado en 1923 el Premio Nobel de Fisiología y Medicina a Frederick Grant Banting compartido con John James Richard Macleod. -
E. Hubble descubre a través de ka observación mediante le telescopio mas grande de ka época, las estrellas que conforman la nebulosa Andrómeda, tratándose de un sistema de estrellas que no se encontraba en la vía láctea
-
W. Pauli, definió el principio de exclusión (también llamado principio de exclusión de Pauli) que establece que dos electrones no pueden ocupar el mismo estado energético (es decir, tener los mismos números cuánticos) de forma simultánea en un átomo. Su hipótesis, en 1931, de la existencia del neutrino, una partícula subátomica, cons
-
La penicilina G o bencilpenicilina fue el primer antibiótico empleado ampliamente en medicina; su descubrimiento ha sido atribuido a Alexander Fleming, quien obtuvo el Premio Nobel en Fisiología o Medicina en 1945.
-
Clyde Tombauygh, fue descubridor del planeta enano Plutón , para localizarlo utilizó un microscopio de parpadeo, con el que comparó fotografías de una región del cielo que habían sido tomadas con varios días de diferencia.
-
En el Laboratorio Cavendish de la Universidad de Cambridge, Cockcroft y Walton construyeron este acelerador de 500 kilovolts, fueron los primeros en construir el primer acelerador de iones positivos, con el que generaron un haz de protones de bajas energías y lo usaron para bombardear isótopos de litio. El resultado de este bombardeo fue producir la primera transmutación nuclear hecha totalmente por el hombre. Por este evento Cockeroft y Walton recibieron el premio Nobel de Física en 1933.
-
El Z1 está considerado como el primer computador electro-mecánico programable del mundo. Fue diseñado por el ingeniero alemán Konrad Zuse, esta era una calculadora mecánica basada en el sistema binario que operaba con electricidad y con la posibilidad de poder programarla, aunque de forma limitada. Hacía uso de relés eléctricos para automatizar los procesos.
-
Meitner formó parte del equipo que descubrió la fisión nuclear, un logro por el cual su amigo Otto Hahn recibió el Premio Nobel.
Es a menudo considerada uno de los más evidentes ejemplos de hallazgos científicos hechos por mujeres y pasados por alto por el comité del Nobel. -
Fue una central nuclear soviética ubicada en Óbninsk, actual Rusia, convirtiéndose en la primera central nuclear civil de la historia.
Tenía un reactor de uranio y grafito, de tipo AM-1 (en ruso, Atom Mirnij átomo pacífico). Generaba 5 MW con solo un 17% de rendimiento térmico. -
Los cinturones de Van Allen son dos zonas de la magnetosfera terrestre donde se concentran grandes cantidades de partículas cargadas de alta energía, originadas en su mayor parte por el viento solar capturado por el campo magnético terrestre. Son llamados así en honor de su descubridor, James Van Allen.
A list shows items. A timeline shows sequence.
Use Timetoast to make dates, milestones, and turning points easier to understand in a clear visual format. Timetoast is a timeline maker for work, school, research, and stories.